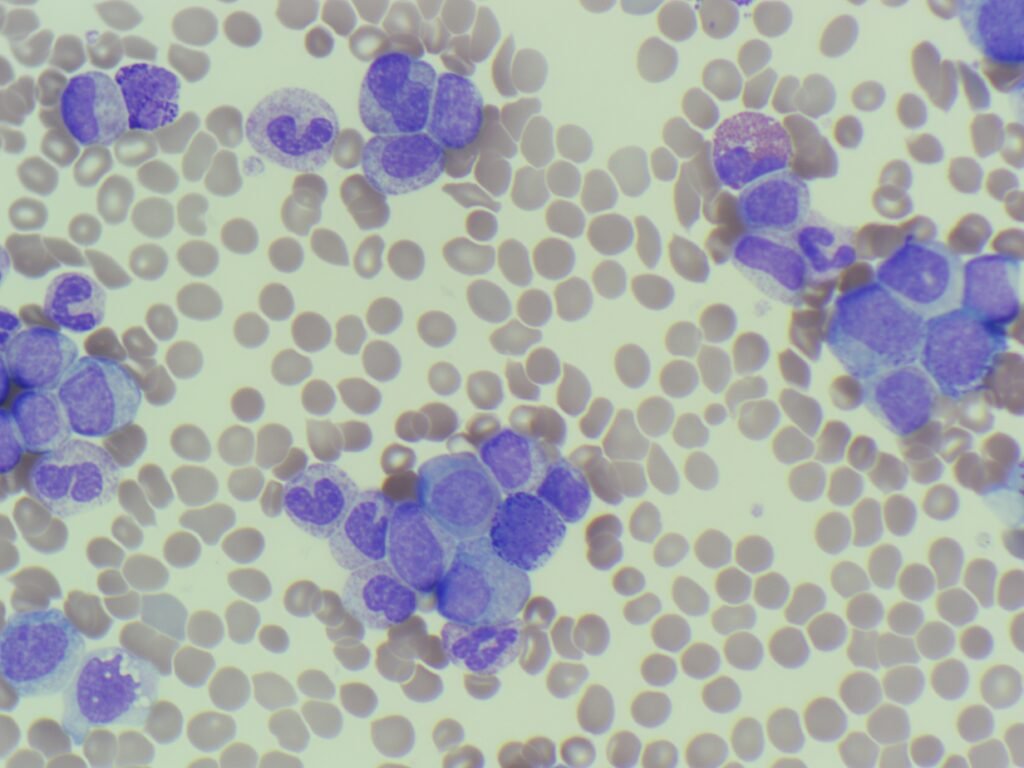

This week’s case began with an urgent call from the haematology Specialist Registrar (SpR) before the sample had even reached the laboratory. A patient had been referred from another hospital and presented to the Emergency Department with a massive clinical picture.
Clinical context
The SpR was so concerned that they requested an urgent blood film and a G6PD assay to be performed immediately upon receipt of the sample. Looking at the initial Full Blood Count (FBC) results, it is easy to see why the clinical team was on high alert.
FBC highlights:
- WBC: 319.64 x 109/L
- Hb: 146 g/L
- PLT: 205 x 109/L

Blood film images:

Look carefully at the numbers and the images. There are two main points that I’d like you to consider:
- Based on the FBC results and blood film images, what is your primary diagnosis?
- Why would the haem SpR specifically request a G6PD screen in this case? What is the clinical significance of checking this enzyme level in these patients?
Post your thoughts in the comments! You can also participate on LinkedIn and Twitter (X).